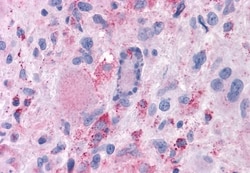
Invitrogen MRGPRX2 Polyclonal Antibody 50 &mu;g; Unconjugated:Anticuerpos

missing translation for 'onlineSavingsMsg'
Learn More
Learn More
Invitrogen™ MRGPRX2 Polyclonal Antibody
Descripción
Percent identity with other species by BLAST analysis: Human, Orangutan, Monkey (100%) Chimpanzee, Gorilla, Gibbon, Marmoset (86%).
Orphan receptor. Probably involved in the function of nociceptive neurons. May regulate nociceptor function and/or development, including the sensation or modulation of pain. Cortistatin-14 seems to be a high potency ligand at this receptor. Cortistatin has several biological functions including roles in sleep regulation locomotor activity, and cortical function. In receptor-expressing cells, cortistatin-stimulated increases in intracellular Ca(2+) but had no effect on basal or forskolin-stimulated cAMP levels, suggesting that this receptor is G(q)-coupled. Has a limited expression profile, both peripheral and within the central nervous system, with highest levels in dorsal root ganglion.

Especificaciones
Especificaciones
| Antígeno | MRGPRX2 |
| Aplicaciones | Immunohistochemistry (Paraffin) |
| Clasificación | Polyclonal |
| Concentración | 1 mg/mL |
| Conjugado | Unconjugated |
| Formulación | PBS with 0.1% sodium azide |
| génica | MRGPRX2 |
| N.º de referencia del gen | Q96LB1 |
| Alias de gen | G protein-coupled receptor MRGX2; G370024M05Rik; MAS related GPR family member X2; Mas-related G protein-coupled receptor G3; MAS-related GPR, member B10; MAS-related GPR, member X2; mas-related G-protein coupled receptor member B10; Mas-related G-protein coupled receptor member X2; MGRG3; MrgB10; Mrgprb10; Mrgprx2; MRGX2 |
| Símbolos de los genes | MRGPRX2 |
| Mostrar más |
Título del producto
Al hacer clic en Enviar, acepta que Fisher Scientific se ponga en contacto con usted en relación con los comentarios que ha proporcionado en este formulario. No compartiremos su información para ningún otro fin. Toda la información de contacto proporcionada se mantendrá de acuerdo con nuestra Política de Privacidad. Política de privacidad.
¿Detecta una oportunidad de mejora?